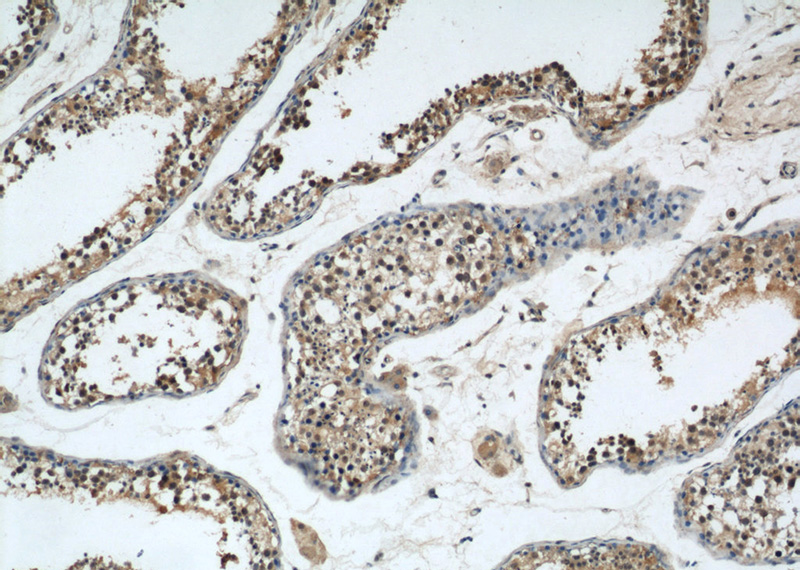

-
Product Name
GSK3B antibody
- Documents
-
Description
GSK3B Rabbit Polyclonal antibody. Positive IF detected in MCF-7 cells. Positive IHC detected in human testis tissue, human prostate hyperplasia tissue. Positive WB detected in mouse brain tissue, HeLa cells, LNCaP cells, mouse kidney tissue, mouse ovary tissue, mouse testis tissue, mouse thymus tissue, PC-3 cells, rat brain tissue. Positive IP detected in mouse brain tissue. Observed molecular weight by Western-blot: 46-48 kDa
-
Tested applications
ELISA, WB, IF, IHC, IP
-
Species reactivity
Human,Mouse,Rat; other species not tested.
-
Alternative names
GSK 3 beta antibody; GSK3 beta antibody; GSK3A B antibody; GSK3B antibody; GSK-3B antibody; GSK3B 216P antibody; gsk3beta antibody
-
Isotype
Rabbit IgG
-
Preparation
This antibody was obtained by immunization of GSK3B recombinant protein (Accession Number: NM_002093). Purification method: Antigen affinity purified.
-
Clonality
Polyclonal
-
Formulation
PBS with 0.02% sodium azide and 50% glycerol pH 7.3.
-
Storage instructions
Store at -20℃. DO NOT ALIQUOT
-
Applications
Recommended Dilution:
WB: 1:500-1:5000
IP: 1:500-1:5000
IHC: 1:20-1:200
IF: 1:20-1:200
-
Validations

mouse brain tissue were subjected to SDS PAGE followed by western blot with Catalog No:111169(GSK3B antibody) at dilution of 1:1000
Immunohistochemical of paraffin-embedded human testis using Catalog No:111169(GSK3B antibody) at dilution of 1:50 (under 10x lens)

Immunohistochemical of paraffin-embedded human testis using Catalog No:111169(GSK3B antibody) at dilution of 1:50 (under 40x lens)

Immunofluorescent analysis of MCF-7 cells, using GSK3B antibody Catalog No:111169 at 1:50 dilution and Rhodamine-labeled goat anti-rabbit IgG (red).

IP Result of anti-GSK3B (IP:Catalog No:111169, 4ug; Detection:Catalog No:111169 1:1000) with mouse brain tissue lysate 4000ug.
-
Background
Glycogen synthase kinase-3 (GSK3) is a proline-directed serine-threonine kinase that was initially identified as a phosphorylating and inactivating glycogen synthase .GSK3B is involved in energy metabolism, neuronal cell development, and body pattern formation.In skeletal muscle, it contributes to insulin regulation of glycogen synthesis by phosphorylating and inhibiting GYS1 activity and hence glycogen synthesis. Researches showed that the crystal structure of human GSK3B, expressed in insect cells, at 2.8-angstrom resolution .This antibody recognize the C-terminal of GSK3B.
-
References
- Chen XM, Bai Y, Zhong YJ. Wogonin has multiple anti-cancer effects by regulating c-Myc/SKP2/Fbw7α and HDAC1/HDAC2 pathways and inducing apoptosis in human lung adenocarcinoma cell line A549. PloS one. 8(11):e79201. 2013.
- Masamha CP, Xia Z, Yang J. CFIm25 links alternative polyadenylation to glioblastoma tumour suppression. Nature. 510(7505):412-6. 2014.
- Wu Q, He J, Mei W, Zhang Z, Wu X, Sun F. Arene ruthenium(ii) complex, a potent inhibitor against proliferation, migration and invasion of breast cancer cells, reduces stress fibers, focal adhesions and invadopodia. Metallomics : integrated biometal science. 6(12):2204-12. 2014.
- Chen XM, Xie XB, Zhao Q. Ampelopsin induces apoptosis by regulating multiple c-Myc/S-phase kinase-associated protein 2/F-box and WD repeat-containing protein 7/histone deacetylase 2 pathways in human lung adenocarcinoma cells. Molecular medicine reports. 11(1):105-12. 2015.
- Xiao W, Jiang Y, Men Q. Tetrandrine induces G1/S cell cycle arrest through the ROS/Akt pathway in EOMA cells and inhibits angiogenesis in vivo. International journal of oncology. 46(1):360-8. 2015.
- Gu GJ, Chen T, Zhou HM, Sun KX, Li J. Role of Wnt/β-catenin signaling pathway in the mechanism of calcification of aortic valve. Journal of Huazhong University of Science and Technology. Medical sciences = Hua zhong ke ji da xue xue bao. Yi xue Ying De wen ban = Huazhong keji daxue xuebao. Yixue Yingdewen ban. 34(1):33-6. 2014.
- Hao YQ, Su ZZ, Lv XJ. RNA-binding motif protein 5 negatively regulates the activity of Wnt/β-catenin signaling in cigarette smoke-induced alveolar epithelial injury. Oncology reports. 33(5):2438-44. 2015.
- Zheng T, Yang X, Wu D. Salidroside ameliorates insulin resistance through activation of a mitochondria-associated AMPK/PI3K/Akt/GSK3β pathway. British journal of pharmacology. 172(13):3284-301. 2015.
Related Products / Services
Please note: All products are "FOR RESEARCH USE ONLY AND ARE NOT INTENDED FOR DIAGNOSTIC OR THERAPEUTIC USE"
